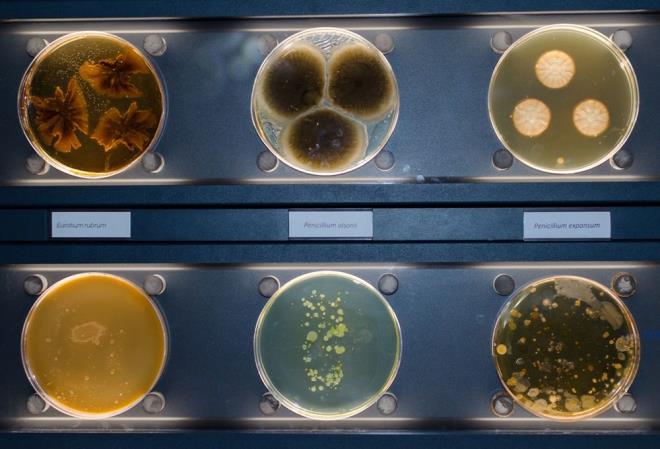
Journal of Exposure Science and Environmental Epidemiology adll bilimsel dergide yaymlanan alma kapsamnda, aratrmaclar, pazar payna ve en ok satan rnlere gre restoranlar ve men elerini (hamburger, patates kzartmas, tavuk kanad, tavuk drm ve peynirli pizza) seti.

Ünlü Fast Food Markaları Kısırlık Ve Kanser Yapıyor
Yeni bir araştırma fast food yediğinizde endişelenmeniz gerekenin gereken sadece kolesterol, yüksek kalori ve karbonhidratlar olmadığını ortaya koydu.
-

ABD'de yer alan George Washington Üniversitesi'nden bilim insanların bildirdiğine göre, fast-food ürünlerinin yüzde 80'inden fazlasında plastiği esnek hale getirmek için kullanılan ftalatlar bulundu.
-

SAYISIZ SAĞLIK SORUNUNA NEDEN OLUYOR Ftalatlar plastikleştirici olarak sanayide kullanıyor. Vinil döşeme ve plastik ambalajlardan sabun ve şampuanlara kadar yüzlerce üründe yer alıyor. Madde, kanser, karaciğer hasarı, kısırlık, tiroid hastalığı, astım ve hatta daha küçük testisler gibi çok sayıda sağlık sorunuyla çocuklarda öğrenme güçlüğü, davranış sorunları ve dikkat eksikliği bozuklukları ile ilişkilendirildi.
-

ÇOCUKLAR ÖZELLİKLE TEHLİKEDE Amerikan Hastalık Kontrol ve Önleme Merkezleri?ne (CDC) göre, insanlar ftalat içeren ürünlerle temas etmiş yiyecek ve içecekleri tüketerek veya ftalat partiküllerini doğrudan havadan soluyarak zararlı kimyasala maruz kalıyor. CDC, çocukların özellikle savunmasız olduğunu, çünkü çocukların buldukları nesneleri genellikle ağızlarına götürdüğünü söyledi.
-

Journal of Exposure Science and Environmental Epidemiology adllı bilimsel dergide yayımlanan çalışma kapsamında, araştırmacılar, pazar payına ve en çok satan ürünlere göre restoranları ve menü öğelerini (hamburger, patates kızartması, tavuk kanadı, tavuk dürüm ve peynirli pizza) seçti.
-

ET ÜRÜNLERİNDE DAHA FAZLA KİMYASAL BULUNDU Hamburger gibi etle yapılan ürünlerin daha yüksek ftalat seviyelerine sahipken, patates kızartması ve peynirli pizzada en düşük seviyedeydi.
-

Bununla birlikte bilim insanları, sipariş ettikleri yiyeceklerin yüzde 81'inin astım riskinin artmasıyla bağlantılı olan DnBP adlı bir ftalat içerdiğini, yüzde 70'i ise doğurganlığın azalmasına ve diğer üreme sorunlarına bağlı olan DEHP içerdiğini aktardı.
-

Araştırmacılar, işleme ve paketleme ekipmanından çalışanların giydiği plastik eldivenlere kadar, gıda tedarik zincirinin herhangi bir yerinde hamburgerler ve diğer ürünlerin i ftalatlar ve yedek plastikleştiricilerle temas etmiş olabileceğini aktardı.
-

Diğer taraftan, George Washington Üniversitesi?nde çevre sağlığı profesörü olan ortak yazar Ami Zota, çalışmanın düşük gelirli Amerikalıların ve beyaz olmayan insanların orantısız bir şekilde ftalatlara maruz kaldığına dair endişeleri artırdığını söyledi. Fast food ABD ve Avrupa'da çok dagha uygun fiyatlı olduğu için daha çok yoksul gruplar tarafından tükeiliyor.
-

Zota, "Dezavantajlı mahallelerde genellikle çok sayıda fast-food mağazası var, ancak meyve ve sebze gibi sağlıklı gıdalara erişim çok sınırlı? diye konuştu.
-

KADINLAR DAHA FAZLA FLATATA MARUZ KALIYOR Öte yandan, 2019 tarihli bir CDC raporu, siyahların beyazlardan daha fazla ftalata maruz kaldığını buldu.
-

Ayrıca, genel olarak yetişkin kadınların sabunlarda, şampuanlarda, kozmetiklerde ve diğer kişisel bakım ürünlerinde kullanılan plastikleştiricilere erkeklerden daha yüksek seviyelerde maruz kaldığı bildirildi.